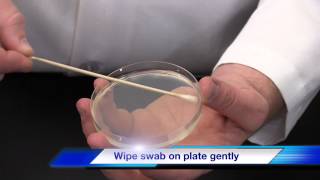

- Pengenceran Bertingkat Mikrobiologi

Tujuan dari pengenceran bertingkat yaitu memperkecil atau mengurangi jumlah mikroba yang tersuspensi dalam cairan. Penentuan besarnya atau banyaknya ... Watch Now
Watch Now
- Surface Sampling Swab

Surface Sampling Swab User Guide for TSC Swabs. Watch Now
Watch Now
- PROSEDUR PENGAMBILAN USAP PERALATAN.flv

KANTOR KESEHATAN PELABUHAN KELAS I TANJUNG PRIOK PELATIHAN PENGAMBILAN SPESIMEN KESEHATAN LINGKUNGAN BAGI PETUGAS ... Watch Now
Watch Now
- Pemeriksaan Rectal Toucher | HMPD SEMAKU

 Watch Now
Watch Now
- metode test DNA

 Watch Now
Watch Now
- Tes Pap Smear

Pap Smear atau Tes Pap adalah pemeriksaan penunjang untuk scrining awal kanker serviks. Teknik ini dilakukan dengan indikasi seperti pernah kontak ... Watch Now
Watch Now
- REAL Graham Test

REAL Graham Test for detection of Enterobius vermicularis Protocol for sampling. More information: http://reallaboratory.com/product/graham-test-safe-clean/ Watch Now
Watch Now
- Kirby Bauer Disk Diffusion Method
Bacteria. Watch Now
Watch Now
- Testing an Antibiotic Using a Disk Diffusion Assay - Kirby Bauer Method

At GoldBio, we make sure each of our products are thoroughly tested to the highest standards. In addition to a typical certificate of analysis (COA), we also test ... Watch Now
Watch Now
- Ovutest Femometer - Cek Masa Subur dengan Suhu Basal

Ovutest Femometer Ovutest Femometer menyinkronkan suhu basal tubuh ke aplikasi Femometer di smartphone Anda untuk merekam, melacak, dan ... Watch Now
Watch Now
- Pap and HPV Testing | Nucleus Health

Visit our website to learn more about using Nucleus content for patient engagement and content marketing: http://www.nucleushealth.com/ The Pap test and ... Watch Now
Watch Now
- How to Use a Petrifilm Count Plate? - Biology Lab Techniques

Tutorial video for using 3M\'s Petrifilm Count Plate system for assessment of coliform bacterial load. Video produced by Dr Guillaume Erard ... Watch Now
Watch Now
- Doing Mewing

Help our Cause! Join our Patreon Community: https://www.patreon.com/orthotropics For Direct Donations: https://www.paypal.me/orthotropics Meal time exercise ... Watch Now
Watch Now
- Ujian Benedict

Ujian Benedict adalah digunakan bagi menguji kehadiran glukosa dalam sampel makanan. Sekiranya ada glukosa dalam sampel, maka hasil akhir eksperimen ... Watch Now
Watch Now
- praktikum parasitologi 1 metode anal swab

UNIMUS DIV Teknologi Laboratorium Medik. Watch Now
Watch Now
- PENANGANAN SAMPEL BERDASARKAN ISO 17025 - KELOMPOK 7

Video ini adalah tugas dari dosen mata kuliah Manajemen Lboratorium. Watch Now
Watch Now
Saturday, September 21, 2019
Metode Swab Test Adalah
Subscribe to:
Post Comments (Atom)
No comments:
Post a Comment